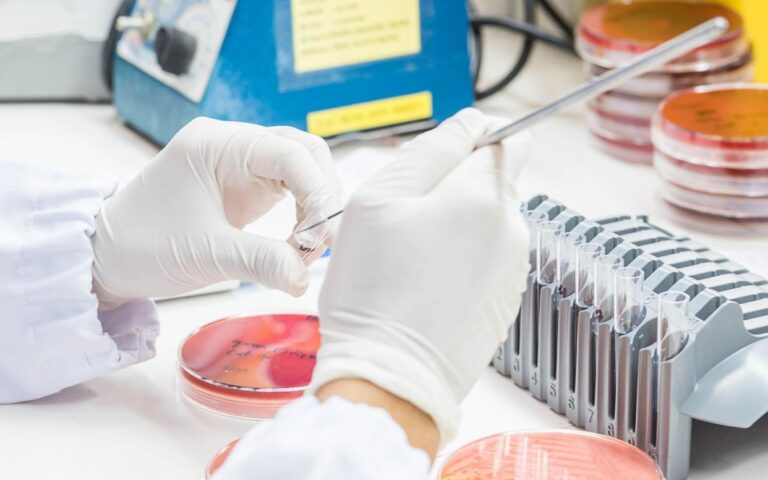

नेपाल हेल्थ न्युज, काठमाडौँ । सूक्ष्म जीव वैज्ञानिक अर्थात् माइक्रोबायोलोजिस्टहरूलाई सुल्झाउन एक दशक लागेको एउटा जटिल समस्या अर्टिफिशल इन्टेलिजन्स अर्थात् एआईले दुई दिनमा समाधान गरिदिएको छ।
इम्पेरिअल कलेज लन्डनका प्राध्यापक जोजे आर पिनाड्स र उहाँको टोलीले केही सुपरबगहरू किन एन्टिबायोटिक प्रतिरोधी हुन्छन् भन्ने पत्ता लगाउन वर्षौँ खर्चिनुभएको थियो ।
उहाँले वैज्ञानिक अनुसन्धानमा संलग्न व्यक्तिहरूलाई गुगलले बनाएको एउटा प्रविधि दिनुभयो। उनीहरूले अनुसन्धान गर्न चाहेको मुख्य समस्या सोधेर दिएको छोटो प्रम्प्टका आधारमा उक्त एआई प्रविधिले ४८ घण्टामा आफ्नो निष्कर्ष निकालेको थियो।
एआईले पत्ता लगाएको निष्कर्षले आफूलाई स्तब्ध तुल्याएको प्राध्यापक पिनाड्सले बताउनुभयो। आफ्नो अनुसन्धान कतै पनि प्रकाशित नभएका कारण एआई प्रणालीले त्यो सार्वजनिक माध्यमबाट फेला पार्न सक्ने अवस्था थिएन।
‘यो कुरा सुनाइँदा म एक जनासँग किनमेलका लागि बाहिर निस्किएको थिएँ। मैले ुएक घण्टाजति मलाई एक्लै रहन देऊ भनेँ। मलाई त्यो कुरा पचाउन कठिन भइरहेको थियो,’ उहाँले बीबीसी रेडिओ फोरको टूडे कार्यक्रममा सुनाउनुभयो ।
‘मैले गुगललाई इमेल लेखेर ‘तिमीले मेरो साँच्चिकै कम्प्युटर पहुँच पाएका थियौ? भनेर पनि सोधेँ’ उहाँले थप्नुभयो । उक्त प्रविधि कम्पनीले ती प्राध्यापकको कम्प्युटरमा आफ्नो पहुँच नभएको बतायो।
एआईले दुई दिनमा पत्ता लगाएको अनुसन्धानका लागि वैज्ञानिकहरूलाई एक दशक लागेको थियो। त्यसपछि आफ्नो अनुसन्धान प्रमाणित गर्न पनि उनीहरूले कैयौँ वर्ष खर्चनु पर्यो।
तर उनीहरूले उक्त अनुसन्धान परियोजनाको सुरुमै सम्भावित परिणामको परिकल्पना गरेका भए उक्त काम वर्षौँ छोटो हुन सक्ने बताएका छन्।
प्राध्यापक पिनाड्सका अनुसार गुगलको उक्त प्रविधिले उहाँको अनुसन्धान प्रतिबिम्बित गर्ने भन्दा थप काम गरेको छ। ‘उनीहरूले मुख्य परिकल्पना मात्र नभएर अरू चार वटा परिकल्पना दिएका थिए र ती सबै अर्थपूर्ण थिए’ उहाँ थप्नुहुन्छ । ‘त्यसमध्ये एउटाबारे हामीले कहिले पनि सोचेका थिएनौँ र अहिले हामी त्यसमा काम गर्दैछौँ।’
सुपरबगको हैरानी
अनुसन्धाताहरूले एन्टी बायोटिक प्रतिरोधी केही खतरनाक कीटाणु अर्थात् सुपरबगहरू कसरी बन्छन् भन्नेबारे अनुसन्धान गरिरहेका छन्। उनीहरूको परिकल्पना के थियो भने विभिन्न भाइरसबाट सुपरबगले पहिले आफ्नो पुच्छर बनाउँछन् र त्यसले उनीहरूलाई विभिन्न प्रजातिमा फैलन सघाउँछ।
प्राध्यापक पिनाड्सले त्यसको सम्बन्ध सुपरबगहरूसँग रहने एउटा साँचो सँग रहेको कुरा अघि सार्नुभयो । र त्यसले नै तिनीहरूलाई एक ठाउँबाट अर्को ठाउँ अनि एउटा जीवबाट अर्को जीवमा पुग्न मद्दत गर्ने पत्ता लगाउनुभयो ।
यो परिकल्पना अनुसन्धान टोलीका लागि अनौठो थियो र कतै पनि प्रकाशित भएको थिएन। अनुसन्धान टोलीमा रहेका कसैले पनि अनुसन्धानको निष्कर्ष कतै सार्वजनिक गरेका थिएनन्।
त्यसकारण प्राध्यापक पिनाड्स गुगलको नयाँ एआई प्रविधि यो अनुसन्धानका लागि प्रयोग गर्न राजी हुुनुभयो । दुई दिनमै उक्त एआईले केही परिकल्पनाहरू सहितको जानकारी उपलब्ध गरायो।
एआईको पहिलो बुझाइ नै प्राध्यापक पिनाड्सको टोलीले गरेको अनुसन्धानको निष्कर्षसँग मेल खायो। एआईले पनि सुपरबग आफ्नो पुच्छरको मद्दतले फैलने निष्कर्ष सुनायो।
यसका पैरवीकर्ताहरूले एआईले वैज्ञानिक अनुसन्धानलाई अझै अगाडि लैजाने बताउने गरेका छन् भने अन्यले यसले मानिसहरूको रोजगारी खोस्ने चिन्ता व्यक्त गरेका छन्।
प्राध्यापक पिनाड्स आफ्नो जस्तै मानिसहरूको पहिलो प्रतिक्रिया रोजगारी गुम्ने भए पनि यसबारे मानिसहरूले सोच्ने हो भने आफूसँग निकै शक्तिशाली प्रविधि भएको महसुस गर्न सक्ने बताउनुहुन्छ । अनुसन्धानमा संलग्न अन्य अनुसन्धाताहरू यो प्रविधि भविष्यमा निकै उपयोगी हुनेमा विश्वस्त भएको उहाँ बताउनुहुन्छ ।
‘यसले पक्कै पनि विज्ञानलाई परिवर्तन गर्छ भन्ने मलाई महसुस भएको छ,’ प्राध्यापक पिनाड्स भन्नुभयो । ‘यो अद्भुत कुराको उपयोगमा म अगाडि भएँ र यसको हिस्सा हुन पाउँदा मलाई गर्व महसुस भएको छ।’
‘एउटा ठूलो खेलमा भाग लिन पाउँदाको अवसर जस्तो महसुस भएको छ। मलाई अन्ततः च्याम्पिअन्स लीग खेल्न लागिरहेको महसुस भएको छ।’ बीबीसी

स्कोलियोसिस के हो ? कारण, लक्षण र उपचार
बिहीबार, जेठ २८, २०८३
डा डिल्लीरमण रेग्मी राष्ट्रिय शान्ति पुरस्कार डा. दास र डा. पोखरेललाई
मंगलबार, जेठ २६, २०८३
विश्व मस्तिष्क ट्यूमर दिवस २०२६, मस्तिष्क ट्यूमरबारे भ्रम र यथार्थ
सोमबार, जेठ २५, २०८३







